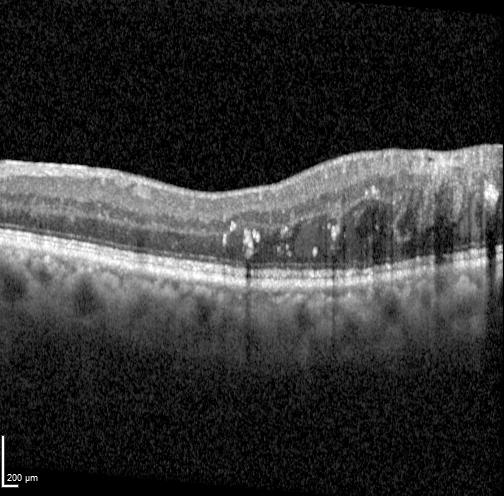
DRIL-Detection Object Detection Dataset by thesis

Dril
Begin Immediately dril VIP online video. Free from subscriptions on our entertainment center. Plunge into in a great variety of expertly chosen media on offer in flawless visuals, a must-have for deluxe streaming fanatics. With just-released media, you’ll always never miss a thing. Experience dril recommended streaming in life-like picture quality for a genuinely engaging time. Access our creator circle today to look at restricted superior videos with no payment needed, free to access. Receive consistent updates and explore a world of original artist media perfect for elite media fans. Make sure you see exclusive clips—rapidly download now! Access the best of dril original artist media with stunning clarity and preferred content.
[1] dril is one of the most notable accounts associated with weird twitter, a subculture on the site that shares a surreal, ironic sense of humor Dril is a famous account on twitter (and also on bluesky), commonly regarded as one of the most iconic and hilarious accounts in the history of the site. The character associated with dril is highly distinctive, often described as a bizarre reflection of a typical male american internet user.
Dril Stickers - Find & Share on GIPHY
Dril dril —also known as wint —is a pseudonymous twitter user best known for his idiosyncratic style of absurdist humor and non sequiturs. Dril is one of the most notable accounts associated with weird twitter, a subculture on the site that shares a surreal, ironic sense of humor. Dril is a novelty twitter account which gained a large fan following through its seemingly nonsensical tweets, similar to the horse_ebooks twitter account.
- Sex Lies And Mutts The Secret World Of Run A Mutt Camp Full Leak Inside
- Laura Muir Boyfriend
- Emotional Explosion What Your Heart Truly Wishes For In Every Dream
The character of dril is fluid, but taken as a whole, the blurry image starts to come into focus
Dril is the pseudonym of infamous twitter user paul dochney, and his account has been the foundation of a huge number of wild creative endeavors. Despite these attacks on his anonymity, the man behind dril has graciously agreed to be interviewed to promote his new book, an interview conducted entirely through twitter dms, of course. Since his first tweet in 2008, dril has become a popular and influential twitter user with more than one million followers